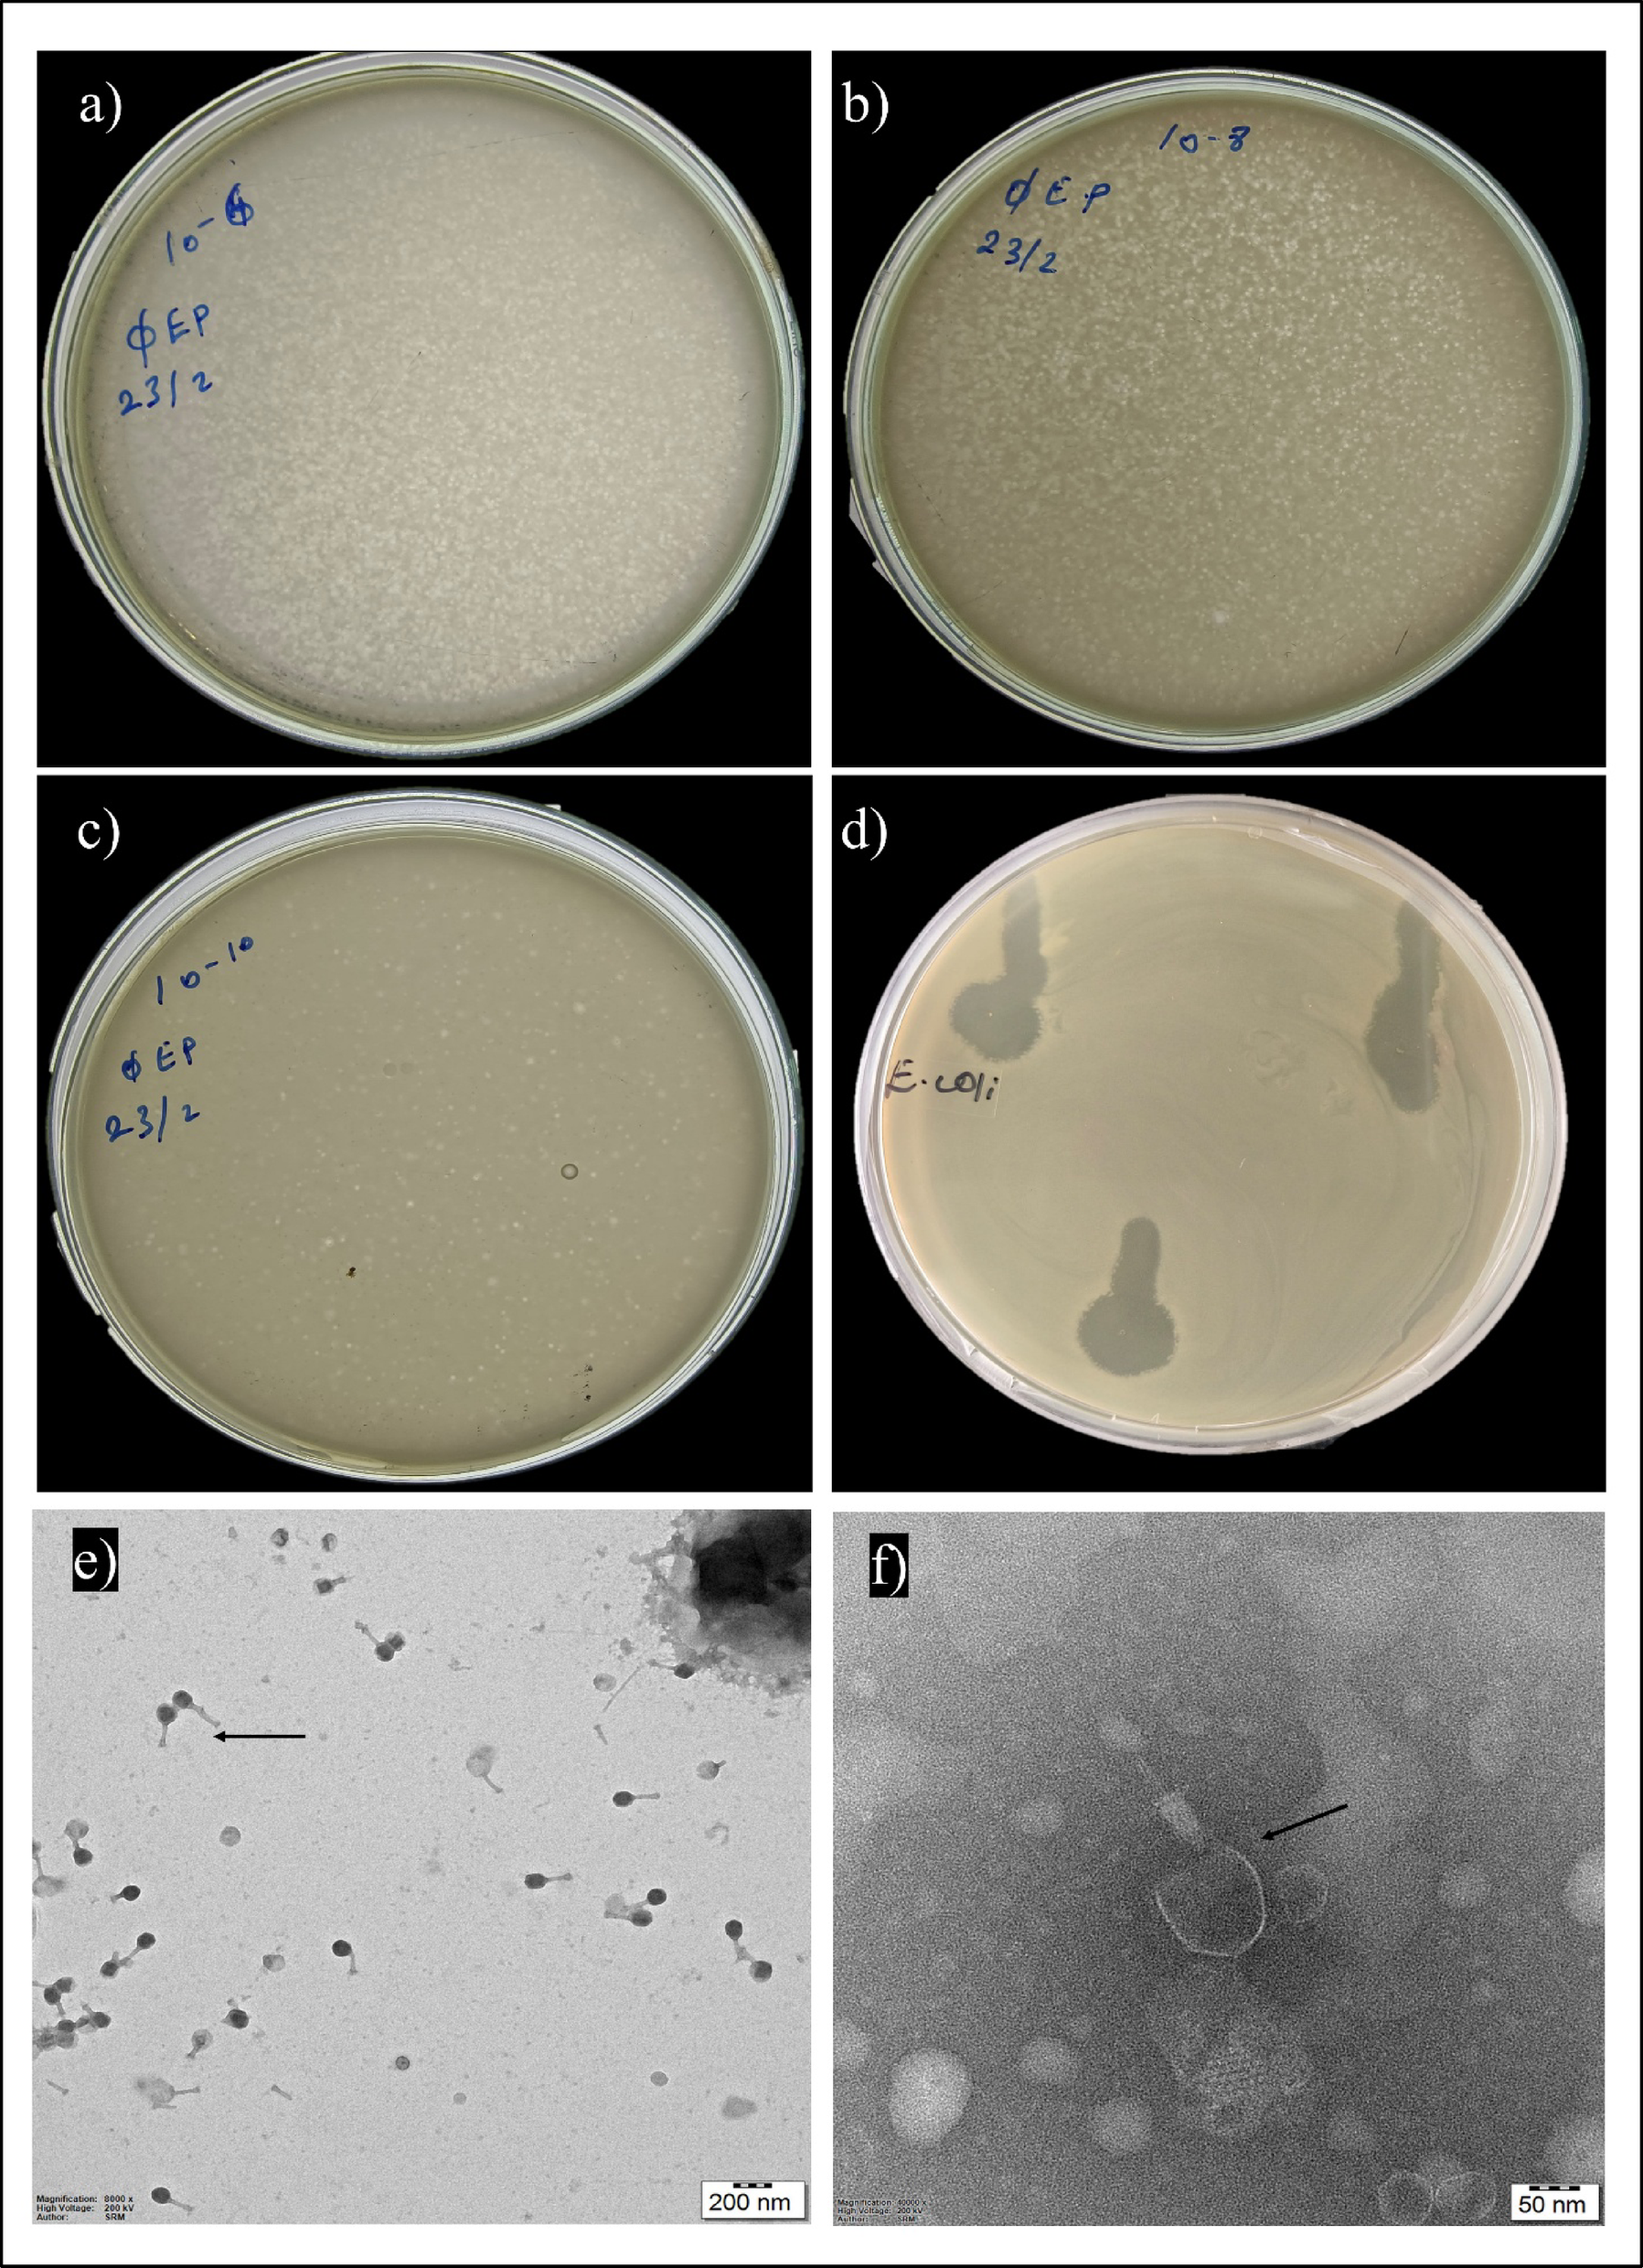
Fig. 3

Fig. 3

Phage characterization: (a-c) Phage titration after lyophilization (1010 PFU/mL); (d) Spot test with 13 mm lytic zone; (e-f) TEM morphology consistent with Myoviridae and phage stained with 2% uranyl acetate.
Phage characterization: (a-c) Phage titration after lyophilization (1010 PFU/mL); (d) Spot test with 13 mm lytic zone; (e-f) TEM morphology consistent with Myoviridae and phage stained with 2% uranyl acetate.